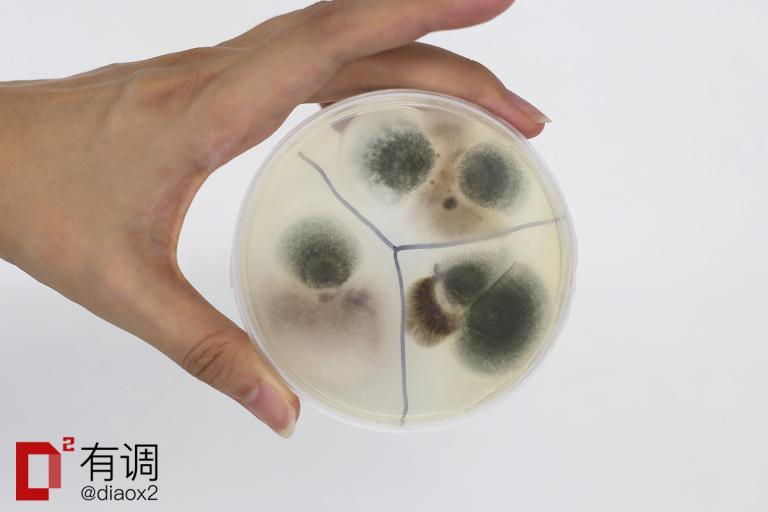
干货分享（买东西的成语怎么说）买东西怎么形容，(图61)

也许你现在还没买到最成功的东西,我们用两年时间帮你以后买的成功一些。
目录
1.嘴巴寂寞?你有这些好选择
2.成为男神从这里开始
3.你离女神只差这一步
4.好好学习,天天向上
5.一年四季都要做的防晒措施
6.个人护理与健康
7.生活必备的日用百货
8.写在最后
测评报告在这里——淘宝上哪家螺蛳粉最好吃?


螺蛳味最香醇的一款,吃完之后口中有阵阵回味。粉稍稍有一些细,因此会更加入味儿,口感Q弹爽滑。配料中的花生给得很豪气,是很多选手两倍那么多。

味道层次非常丰富、有辨识度,汤底浓稠又不会太油腻,鲜辣爽口、酸香过瘾,每次都被评委们抢到一根都不剩。配料十分丰富、量大,倒出来能铺满整个儿碗面。
辣油味道非常香,倒在煮好的粉上一拌,连不吃螺蛳粉的同事闻了都赞不绝口。
评测报告在这里——方便面之外还有哪些好吃的速食品?

能吃出熟油辣子的香味!又香又辣!素菜和粉皮都很入味。全素选手征服了一群肉食动物,始料未及!每轮都被抢到只剩辣油。
友情提醒:非常辣,不太能吃辣的人可能受不了。

只为粉条都值得一试。非常独特的湿粉条,越泡越入味,每轮都被大家抢到渣都不剩。调味层次丰富,咸鲜为主,麻辣为辅。辣度适中,嫌不够辣还可以蘸干料。
友情提醒:非常咸,口淡的受不了,口重的很下饭。可以不放全部底料,只放3/4。
评测报告在这里——淘宝 芝士蛋糕 哪家强?
好利来的这两款半熟芝士在评测过程中每次都被抢着吃光。

原味的口感轻盈,完全没有面粉感、也不噎得慌。吃到中间感觉很细腻,不会流心,但却十分丝滑。

榴莲的乳酪香和榴莲香都很明显,两种味道融合得很好,吃下去让人感觉榴莲和乳酪天生就应该在一起。

所有乳酪蛋糕里蛋糕体最为绵密扎实、湿润清甜 。作为轻乳酪来讲,口味十分清爽、却不寡淡。用料感觉很新鲜,不会有偏酸、偏甜的情况出现。
评测报告在这里——哪个牌子的进口牛奶和进口麦片好?
乳白色大颗粒酸奶球配上粉红色的草莓干,仿佛粉嫩的少女正等人摘采,而这位粉嫩的少女就是我们的ICA草莓酸奶燕麦片。

ICA吃起来感觉内容丰富,酸奶球和草莓干的所占比例很高,玉米片也中和了整个口味的甜度,使其多了一分谷物的香气,干吃和拌酸奶吃的评价普遍很好。
为大小不一、不规则的颗粒,整体大小是麦片中偏大的,奇形怪状像石头,适合干吃。

群众普遍反应干吃起来很不错,比较有嚼劲,不过拿来泡奶拌酸奶的吃法就见仁见智了,大家可以自己探索隐藏吃法。
评测报告在这里——除了老干妈还有什么选择? 17款下饭酱满足你的味蕾
一款吃起来像在吃肉的香菇酱。

香菇占主要原料,含量超过70%,且原料采用的是有着“菇中精品”之称的西峡香菇。香菇香味浓郁,咸辣刚好,搭配馒头、粥、面包都非常美味。适合热爱浓郁菇味的朋友购买。

一打开就能闻到明显的辣椒香,辣度刚好,甜咸适度,仔细品尝还会有回甘。如果你吃腻了老干妈风味豆豉,还想要另一款类似的百搭辣酱,那么我们强烈推荐你购买川崎辣酱。
评测报告在这里——那些排名全球十大最好吃的泡面真的有那么好吃?
评测时全体评测员一致好评的泡面!

浓郁的面汤飘着肉香,几颗枸杞浮于汤中,配上青绿的菜叶,加以筋道的面条,吸溜一口,好吃!
骨汤+蒜的组合,你想试试吗?

汤味浓厚,蒜香扑鼻,配上滑糯的面条,非常不错,让人回味无穷。尽管面汤有一丢丢油腻,但还是值得尝试!
洗面奶的品格报告——什么牌子的洗面奶最好?
润肤露的评测报告——对于IT 型男有哪些护肤品值得推荐?
资生堂著名的男士“大白(●—●)”洗面膏。

泡沫厚重绵密洗感好,各项表现都很突出,清洁力不错。洗后没有明显的干燥或紧绷,也没有刺激或过敏现象。最大的缺点,就是没有缺点。

清洁能力很强,同时含有炭颗粒,更适合出油较多、需要较强清洁能力的调友们。但需要注意清洁能力过强会对皮肤造成损伤,最好配合温和的洗面奶日常使用。
保湿滋润力超强、有不错的控油效果、剃须后使用不刺激、清新的古龙水香气...

如果你不知道自己是什么肤质,或者皮肤明显地干燥紧绷,嘴角起皮,就选它没错啦!
控油效果强、补水力不错、吸收快且清爽无负担...但含有酒精,对敏感皮肤来说有些刺激。

总的来说,非常适合皮肤偏油的男同胞们购买!
高端款中非常值得购买的一款。

完美的剃须能力和踏实厚重的造型让人颇具安全感,无论送人或是送己都非常合适。非常适合对胡须清洁度要求较高、追求极致的调友购买。
平价款中表现十分优秀的选手,只要149元!

虽说在清洁能力、使用舒适度上略有不足,但联想到149元的价格,这些缺点都变得可以原谅,推荐追求性价比的调友购买。
蝉联两次男士内裤评测冠军,当之无愧的有调之选。

舒适度方面,透气性和弹性的表现都异常优异;洗后的起球程度和变形程度都非常低。不管是胖子还是瘦子,都可以放心买买买!

作为国产年轻小众品牌,螃蟹秘密一直有自己的好口碑。评测员评价说:从性价比的角度,诞生于某宝的品牌(螃蟹)可能会相对物美价廉些,包裹性不错,透气性有些不足。如果你觉得舒雅太贵,那螃蟹秘密也不错哦。
友情提示,码数偏小,建议买偏大一码。
如果你觉得前面两款内裤配不上你傲人的大兄弟,那这款CK你可别错过。

Calvin Klein并不是这个世上最好的内裤,但在评测的8个中高端品牌中还是最好的,美貌与舒适及功能并重。
评测报告在这里——如何选择吹风机?
电吹风评测中的有调之选!能给头发带来极致的顺滑和光泽感,让你的秀发每天都能美美地柔顺闪亮。

除了好用,双11当天这款电吹风还有大优惠。原价999元的电吹风只要599元!还有6期免息的分期优惠!一个月只需100块,就能有一头好看的头发,超划算der!
如果你觉得NA45太贵,那NA30则是很好的极具性价比的选择。在500元以下的电吹风中,表现最好的就是它了。

评测报告在这里——有哪些好用的指甲油?

无论涂底油与否,都非常好剥落,且剥落后对甲面损伤较小;干透、成膜的速度很快。不仅如此,还价格便宜,性价比高。
没有痛感、安全、效果感人的脱毛刀。

刀片周围配有含有芦荟精华的润滑板,遇水拉丝,保护皮肤。而且刀片间隙较大,用水一冲就没有卡毛了,几下就能剃净全身。

嘉娜宝适合用于四肢大面积部位,味道宜人同时脱毛效果不错,不过过于粗硬的腿毛还是放弃吧。
凡士林 身体喷雾-芦荟

质地轻薄、不油腻、延展性好。但保湿上可能不够惊艳,更适合皮肤偏油的朋友购买。
有鸡皮烦恼的朋友们只要用上这款身体乳,就可以开心地走向“尽享丝滑”的道路。

“用了三四次以后皮肤明显光滑了不止一个度,忍不住想炫耀自己滑溜溜,洗完澡涂上它都觉得全世界都配不上自己了。”说的就是它!
这款身体乳目前有瓶身透明/不透明两种包装哈。

这款樱花润肤乳,有调评测团男性家属是这么评价的:“味道我很喜欢,如果有一个女生在合理的距离让我闻到这个味道,好感应该会急速提升。”除了味道撩人,涂完后皮肤还特别有光泽感,在光线好的地方看起来bling bling地非常美。

砂质细腻柔和,亲肤水润!按摩全身简直是美容院级质感。用完全身清爽不干燥,非常舒服。对了,它对鸡皮也有奇效哦。

精油丰富颗粒细腻!滋润力MAX,洗完特别滋润,连润肤乳都省了,还有约3小时的留香。对鸡皮的效果立竿见影,评测员评价说“冲水的时候感觉自己滑得像一条蛇”。
在评测中得到所有评测员认可的梳子。

不管是在处理打结还是按摩头皮等方面都表现不错,使用后头发柔顺有光泽。
早已火爆全球的TT梳,易打结发质的本命。

几乎每个用过TT梳子的姑娘,都会被它处理头发打结的能力给惊到!就连发根处的连环结都可以轻松梳开,加上小巧方便的外形,放在包里能随身携带。
单项表现都非常突出,综合分数将其他卫生巾远远甩在身后。

唯一要控诉的就是背胶粘性太弱,在安全内裤上粘不牢,也存在背胶残留的问题。但是面对如此牛X的吸收速度和吸收量,这些小问题都可以忽略不计了。

大名鼎鼎的液体卫生巾,在评测中没有达到TOP3的水平,但也还不错。评测发布后也有无数用户为它疯狂打call。
推荐给敏感肌的朋友。表层是纯棉材质,而不是可能造成过敏的化纤。

需要注意的是,选择纯棉意味着牺牲一部分使用感受。根据评测结果:纯棉表层的吸收速度表现普遍不好,并且比起化纤成分更容易反渗。
纯棉表层透气性不错;防侧漏设计,吸收量可达60ml;吸收速度尚可,反渗情况比较糟糕,使用中可能会有潮湿感。推荐敏感肌朋友在量大的日子使用。

敏感肌朋友量少的日子也可以用高洁丝这款,吸水速度和防侧漏与美国的爱米莎不相上下,反渗能力还优于爱米莎,但因为棉质表层比较松软,非常容易摩擦起球,而且吸水量不大。
不论你是学生党还是上班族,多多多少少都有用笔用本的需求。如果你在纸笔方面有些许困惑的话,有调出品的文具系列评测刚好能帮到你。
0.5mm中性笔评测中综合素质第一名的选手,在多个维度的评比中都获得了满分。

书写流畅、油墨速干防水,同时价格上也十分合理。总的来说,作为日常用笔,这支笔非常合格,长居调友无限回购清单榜首。
国货荣光!KACO这个在2011年诞生于上海的国产文具品牌在0.5mm中性笔评测中展现出了不俗的品质。

书写流畅,颜色饱满;油墨干得较快、防水;握持舒适,同时外形简约清爽。总的来说,是一支里外都让人满意的好笔。
书写流畅度是本次参与评测的100款笔中当之无愧第一名,超级顺滑,能令你惊讶的那种!

作为一个直液式的水性偏强的笔,却是完全防水的,缺点就是干燥速度比较慢。除了图上的颜色,还有多种配色可选,综合来看买一支当随身携带的签字笔再适合不过啦!
这款三菱UB-150综合分数在本次0.38mm中性笔评测中排名第一!

流畅度满分,速干性满分,耐水性超好。使用中虽略有积墨,但影响不大。颜色上有黑、 蓝、 红3种墨色,满足日常使用。虽然价格略高于一般的中性笔,但绝对物超所值。
一支没有硬伤的笔,各方面维度非常均衡,总体使用愉悦,最重要的是,便宜啊!

流畅度不错,出水不冲。笔杆偏细,长久握持会累,舒适度评分不高。黑、 墨蓝、 蓝、 红4种颜色,适合学生党写笔记。和上一款比价格更亲民,用着不心疼。
好马还需配好鞍,好的笔当然也需要配好的本子。这里为大家推荐两款构造不太一样,又都质感满满的笔记本。
两次中性笔评测中使用的本子!

它还能很好地把控墨水尤其是彩墨的表现力,内页颜色不黄不绿,虽然不护眼但是不会引起颜色偏差。除了评测款,还有多种大小、样式可选。
书写感受一流,钢笔友好,甚至比中性笔更友好。整体感受完全不辜负“为书写而生”的广告语。

综合来看,在手感、不洇墨程度、不透纸程度、颜值几个维度均有高于均值的表现,吸水情况也处于平均水平。
在亚马逊在售的Kindle系列里价格最低,却同样功能强大。

如果你对阅读灯没有需求,同时也不怎么看PDF文档,那么Kindle入门版则是你完美的选择!
在使用手感和Kindle Paperwhite大同小异的情况下,Kindle入门版以更亲民的价格和更快的翻页速度,更能戳人内心!
今夏有调接连7弹防晒评测不知都看了没有?看过的宝宝是不是都get到了一年四季都做好防晒的必要性呢。
有调君在这里给大家推荐几款性价比极高的防晒措施,包你一年四季都白的发光。

很多人用传统小金瓶都会过敏或者爆皮,这款比起传统的摇摇乐版,更加滋润温和,干皮妹子们超级喜欢,油皮有个别会反映控油能力不强。亲测洗面奶就能洗净~

新碧这款防晒值高达SPF130,真是吓掉下巴了,实验证明防晒能力确实不俗,但是防水能力并不像官方宣传那么厉害,保险起见推荐日常使用。

综合表现排名第一,各项分数也都非常优秀,被我们选为“有调之选”。既防晒又隔热,就算遇上妖风肆虐的天气,只要你还撑得住伞,它就不会损坏。

考虑到出行的方便,我们推荐这款“手机伞”给大家。不过,五折伞的抗风性都较弱,如遇间歇性妖风有被掀翻的风险,姑娘们使用时要小心哦~
评测报告在这里——能推荐一些防晒衣的牌子吗?

非常轻,收纳起来极小极轻,迷你包都能放下!太阳天在外面穿有一点点热,但是可以承受。重点是,相比于其他防晒衣这个价格简直太太太太便宜了!
测评报告戳这里——如何选购电动牙刷?
这个组合是33款电动牙刷中体验最棒的一款,也是入门款牙刷评测的有调之选。

钻石刷头十分好用,振动频率虽然不是这几个里面最强的,但感觉清洁能力是最强的,很明显地能感受到牙齿缝隙清洁干净了。根据电动牙刷老司机的反馈,和飞利浦旗舰款9系真的没大区别!

如果你觉得飞利浦有些超预算,那素士这款也不错。上嘴的实际刷感很不错,虽说和飞利浦钻石刷头比有些小不足,但整体看可以说是极具性价比!而且颜值还很高!

又一款国产荣光!适用面积大,CADR值高,极具性价比。虽没有Blueair、巴慕达等品牌、设计加持,但如果你只需要一台简单好用的空气净化器,352绝对够了。
不知不觉又到了雾霾季,想在阴霾之下更好地保命,口罩是必不可少的。
一款适合绝大多数人的好口罩,不管你是巴掌扁平小脸还是逆天立体大脸,都可以考虑。

密合性:200+ / 200+ / 200+
过滤标准:P95 | 实测过滤效果:99.5%
呼吸阀:有
产地:美国/中国
注:密合性三个数值分别为高鼻梁、亚洲女、亚洲男,超过 100 即通过测试。下同。
普适于所有脸型。虽然价格不太美丽,但是一分钱一分货、一块钱一条命,值得购买,特别是小脸或是扁平亚洲脸的朋友,更应该考虑购买。

密合性:200+ / 171 / 200+
过滤标准:N95 | 实测过滤结果:99.1%
佩戴方式:头戴/耳戴
呼吸阀:有
产地:日本

对脸型不太夸张的5-12岁儿童都适用,绝对是对孩子最好的防护。
评测报告戳这里——哪个品牌的避孕套(安全套)使用体验最好?好在哪里?
冈本001以佩戴贴合度、佩戴后丁丁的颜值、以及战斗中的快感,三项维度中稳定的发挥,坐上了评测的头把交椅。

因为采用的不是乳胶材料,虽然损失了部分弹性,但套套本身的气味非常清淡,再加上超薄的设计,非常适合喜欢不戴套的朋友哟。
此外,杰士邦动感大颗粒的表现令人十分意外,获得绝大多数评测人员的喜爱。

杰士邦动感大颗粒的颗粒大小更适中,不至于像杜蕾斯那样扎人,也不至于像冈本PPT那样没有明显的感觉。如果你偶尔想要尝试凸点套套,可以买来一试。
一张图告诉你注意清洁有多重要:
评测报告戳这里——手机、键盘的细菌比马桶多是真的么?
一款性价比极高,小巧便携,十分适合出行及日常携带的免洗洗手液。

使用感超级棒,像是在涂抹玻尿酸,润滑不黏腻。硬塑料质地的瓶子,不容易被挤烂,瓶上自带铝合金D字挂扣,随你挂包上挂衣服上都可以。

有独立单片包装的湿巾,一打开就闻到淡淡绿茶味。湿巾含水量比较少,擦完干的快,成分安全性高,肤感清爽舒适。独立包装的设计,十分适合放在包包里随身携带。

40片一包的大容量装,十分适合放在车里、办公室,或在人数较多的出行时带上几包。除菌能力棒棒的,成分都是无毒不刺激的。湿巾含水量比较大,攥一下都能挤出水,不用担心湿巾变“干巾”。香味有点浓,擦过手之后手上会留下淡淡的味道。
评测报告戳这里——什么牌子的漱口水好用呢?
完全颠覆了我们对于漱口水的传统体验,清淡温和,口感一级棒!

此外,化学添加成分少,除口臭效果拔群,是我们8款漱口水评测中,评测员一致认可的最棒的产品!
祛味能力超棒且持久,吃蒜后那一言难尽的味道它也能完美应对。

但需要提醒的是,这款口喷的味道争议很大。有人说是消毒水味,有人说是药水味,有人说是淡薄荷水味...介意的朋友请谨慎购买。
如果说上一款口喷的特点是祛味能力超群,那这款口喷的特点则是让人印象深刻的清凉醒脑的薄荷味。

在颜值上,独特的扁平式设计加分不少,随时随地都可以不尴尬地喷一喷。
评测报告戳这里——出门旅游十天半个月的,内衣裤带很多脏了就扔还是边走边洗着?
如果你对一次性内裤的印象还停留难穿、不卫生、像纸一样,那你就真的凹凸了。现在的一次性内裤基本可以达到普通内裤的舒适度,而且非常干净卫生。出游的时候带上几条,真的是方便省心到飞起。

穿起来和普通内裤比没有太大的区别,包装上每一小条都有用心的小包装。整体尺码偏小,建议选购大一号的。

这款内裤整体偏宽松,贴合性和包裹性一般,适合身材威猛或不在意包裹性的男士购买。材质上有种纸尿裤的感觉,刚开始穿会感觉不适,但穿上一阵子后也没有不舒服的感觉。
评测报告戳这里——天冷了!有调喊你穿秋裤!

哪哪儿都好的秋裤!评测中男性评测员一致推荐。性价比满分,裆部设计十分优秀,穿着没有不适感。优衣库作为年年双11当天最快售罄的品牌,今年你可要抓紧剁手哟。

女性评测员一致推荐的秋裤!在保暖上,是不可动摇的第一名;面料亲肤柔软,手感好。但特别的面料特性也带来了弹性不足的缺点,想买超紧身秋裤的小仙女还是谨慎下手哦。
评测报告戳这里——哪些品牌的毛巾值得推荐?

非常适合跑步、健身房做器械等时候使用。轻薄,就像毛巾界的护垫,叠起来超小一块,轻到没重量。冷感设计,运动的时候擦脸或是搭在脖子上都会有微微凉意。吸汗量不错,干的还很快。

适合游泳等需要大量吸水的运动。吸水量超大,纯棉的材质加上巨大的面积,造就了它最大的吸水量;吸水性超强,随便擦擦就能吸掉皮肤上的水分;亲肤性也很不错。但因为是纯棉的材质,干起来比较慢,大家可以趁双11多屯几条换着用呀。
于卷纸评测中获得“纸质最坚韧”奖!

坚韧的纸质给你在擦屁屁时提供强大的安全感。在柔软性方面,擦屁屁没毛病,擦鼻子就算了。

论纸巾的柔软度,恐怕市面上还没有产品能出大王和妮飘之右。

柔软系列抽纸,不仅手感爆棚,diao感也比较爆棚。具体使用体验还请各位自行感受。总之!我们建议鼻炎or感冒患者or你懂的人群购买这两款抽纸!
评测报告戳这里——如何选购垃圾袋?
这里给大家推荐的是评测中三位获得“有调之选”的选手。垃圾袋看似不起眼,挑起来实则拥有大学问。好的垃圾袋有魔力,能给生活带来巨大的幸福感。不信?买来试试?



经济适用型选手!

样式简洁大方,毛绒柔软蓬松,价格也很是公道。它没有像贵妇型选手Christy一样好到天际,但也挑不出大毛病。
价格百元左右,是一条性价比非常高的浴巾。

各项指标都达到了一个较高水准的平衡,在表现上可以说是没毛病、没短板。
评测报告戳这里——睡眠耳塞好用吗?应该如何挑选?
一款全能且极具性价比的选手!

隔音效果很棒,再也不用忍受宿舍的闹钟声、邻居的装修声、旅途中熊孩子的吵闹声。质地柔软,透气性赞,佩戴舒适度甩其他耳塞几条街。
如果睡姿多样、青睐良好的透气效果,这款枕头一定不能错过。

整体质感好,枕头提供的贴合和支撑恰到好处;两侧高低不同的设计,可以适应更广泛的人群和睡姿;透气性好,枕心表面布有大量透气孔,睡得非常凉爽舒适。
但是,它有乳胶的淡淡奶香,不适应的朋友请谨慎购买。
评测报告戳这里——无印良品的颈枕与cabeau的颈枕哪个好?什么牌子的颈枕好用?

一款有超强支撑力的枕头。加高支撑条设计可以充分支撑颈部,哪怕背后没有椅背也可以舒服的靠着,不会像普通U型枕那样必须顶着东西才有承托力。配合着温感记忆棉,头可以很舒服地陷在侧面。

适合喜欢软枕头的朋友!虽然填充物是“颗粒”,乳胶颗粒的颈枕在开封后迅速地膨胀,更像一个灵活变形的乳胶枕,非常的一体成型,流动性不高但又非常舒适。两端的按扣设计让脖子与颈枕简直亲密无缝,粗脖子细脖子都可以使用。

三口气就能充满,便携度max!充气口很大,有个小挡板,三口气即可充满,完全不会边吹边漏。放气的时候只要一推挡板一挤压,就能立刻放空。在舒适度上和其他正儿八经的颈枕比还是有不足的,但整体已经秒杀一众充气颈枕。
评测报告戳这里——有哪些袜子品牌值得推荐?为什么?

让许多试穿员大赞“太舒服了”的船袜。材质特别,软厚软厚的,因此有一流的脚感。脚汗克星!在吸汗及除臭上有异于常袜的表现,两位非常爱出脚汗的试穿员都在为它打call,被评价为“无论你有多少脚汗它都能给你吸收得干干净净”。

一贯平价又良心的迪卡侬的船袜表现也非常不错。弹性特别棒,因此适合正常脚码以及脚大的朋友。即使是40码脚的女生,在穿迪卡侬的时候都不会觉得勒脚。

一款十分适合逛街、做轻量级运动时穿着的船袜。在编织上采用了3种工艺,脚趾部分无接头,脚背处是特别的网格设计,透气性满分。袜子中部包括脚底部分用弹性材料做了加强,增加包裹性。总的来说穿起来十分舒服。
评测报告戳这里——有什么坚固、防晒、防水的伞推荐?

获得“有调之选”的就是总分排名第一的Subtle双层晴雨伞。Subtle是一个香港的潮牌,非常受年轻人欢迎,这款雨伞的外形、实测数据和使用感受都很不错。

可以晴雨两用。便携性不如五折伞,需要装在单肩包或者双肩包里,但是抗风性更强,更加耐用。
评测报告戳这里——小白鞋如何清洗?
要说小白鞋那可是至少人手一双,但让人苦恼的是脏了的小白鞋非常难清理。如果不想送洗鞋店,你还有这些好选择:

自带海绵刷头,但是刷头非常容易损坏,因此更适用于皮革材质的鞋面。

量!大!实!惠!且适用于各种鞋面。但洗的时候需要配合刷子or海绵一起使用。
评测报告戳这里——国内厂商纷纷发布AI智能音箱,从各方面看,哪家更有胜算呢?
就算智能音箱不在你的双11购物list里,那也一定要入这款天猫精灵!毕竟活动期间只要99元,买回家听歌或是日常调戏都非常美滋滋呀~更何况天猫精灵还十分机灵,基本什么要求都能给出答复。

天猫精灵正在举行双十一超级会员特价活动:11月10日22点前,原价499元的天猫精灵,领券后入手价仅为99元!
见过会吐槽的,没见过连自家老板都敢黑、敢吐槽的产品,我们尝试点播了雷军的歌,小爱同学瞬间就传出熟悉的声音:“Are are are you OK?”

如果你是小米的粉,那我们强烈推荐你买回家和其他智能家电进行联动。
评测报告戳这里——好用的蓝牙耳机有哪些推荐?
在21款蓝牙耳机评测中获得“有调之选”称号的选手。

在评测中得到了最高分,佩戴稳固、音质出众,再加上靓丽的颜值,各方面表现都很全面,整体感觉让人挑不出毛病。

平价好选择!虽说操控有点碍事,但其他方面在耳挂式耳机中均表现出色,而且听感优于大部分低价位耳机,离高价位耳机差距也不大。如果爱好运动的话,那么这款运动耳挂是不错的选择。
评测报告戳这里——有哪些比较耐用的旅行箱品牌?
综合登机箱评测的各个维度,综合表现最好、我们最推荐的产品。

自重轻盈、轮子顺滑无比,具备一款登机箱所需的基本素养。额外有扩容式设计,能够解决一时行李过多收纳困难的尴尬。外壳耐磨,多次摔砸依旧如新。
法国大使 Karat 这款行李箱最独特的地方,就是钻石造型的外壳,通过了所有暴力测试,表现非常出色。

专利设计的双层安全防爆拉链,除了提供了良好的安全性 ,防水效果也很好。但它的内置拉杆设计不周,浪费了不少内部空间,收纳的行李会稍微少一些。
评测报告戳这里——有哪些物美价廉的行李箱?

最具性价比的选手!是推荐款中最便宜的。使用起来没有大毛病,价格超低随便用不心疼。

这位极具少女心的选手只看脸就把持不住了,但她不仅好看,还很耐用。没有明显缺点,价格也不贵,拉着拍照非常可爱。

实力网红!在33款行李箱中获得了不错的成绩,多次摔砸都没有损坏,更有小米品牌信仰加持。但自重较大,介意的朋友慎选。
希望大家能找到最适合自己的那一款。